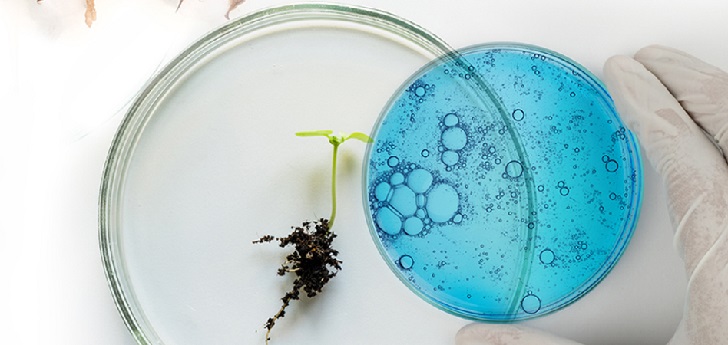

H&M sigue apostando por la sostenibilidad y premia al algodón de laboratorio de Galy
La compañía brasileña con sede en Estados Unidos está especializada en el uso de la biotecnología para el cultivo de algodón en un laboratorio.
1 abr 2020 - 16:00
El algodón de Galy se hace con el premio Global Change Award de H&M. La compañía brasileña con sede en Estados Unidos está especializada en el uso de la biotecnología para el cultivo de algodón en un laboratorio.
La empresa ha recibido un premio de 300.000 euros por parte del gigante sueco de distribución de moda con el objetivo de continuar desarrollando el negocio. “Las innovaciones ganadoras ayudarán a nuestra industria a reinventarse y, con suerte, inspirarán a otros a encontrar también nuevas soluciones”, ha señalado Karl-Johan Persson, presidente de H&M.
Los otros finalistas del premio han sido la estadounidense Werewool, especializada en la fabricación de tejidos elásticos a partir de proteínas; la india TextileGenesis, de blockchain; la estadounidense Zero Sludge, especializada en la separación de fibras de tejidos desechados, y la francesa Airwear by Fairbrics, que convierte los gases de efecto invernadero en poliéster.

































